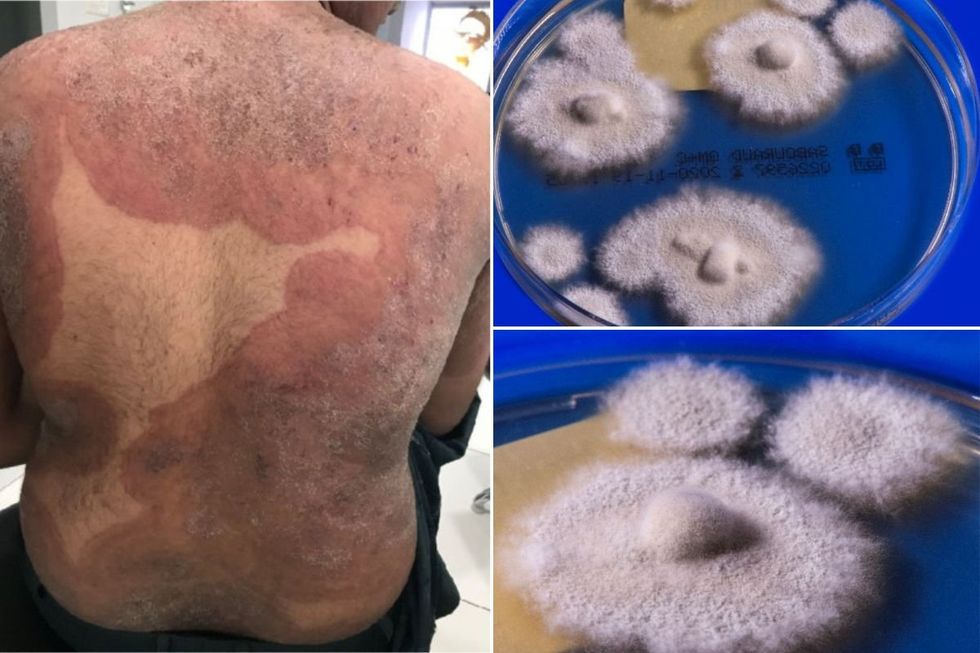
fungus in petri dish and man with rash

Drug-resistant 'super fungus' attacking bum and groin surges 500% in UK - 'It's becoming a big problem'

Infected individuals are being urged to avoid skin-to-skin contact
Don't Miss
Most Read
A drug-resistant fungal infection that was virtually unknown in Britain three years ago has increased by almost 500 per cent, according to alarming new figures.
Trichophyton indotineae cases have jumped from only 44 before 2022 to 258 by March this year, data revealed at last week's ESCAIDE conference in Poland showed.
"It's becoming a really big problem in the UK," Professor Darius Armstrong-James from Imperial College London told The Sun.
The fungal expert expressed serious concerns about how frequently new cases are appearing in hospitals, though he admitted uncertainty about whether it might reach endemic or pandemic levels.
The fungus has evolved to resist conventional treatments
|MDPI
The UK Health Security Agency has confirmed it's "monitoring a rise" in the antifungal-resistant infection, which first emerged in India in 2014 and has now reached more than 20 countries.
The infection requires patients to endure lengthy hospital treatments with itraconazole, a medication that poses risks of severe toxic effects on the heart and liver.
Standard antifungal medicines no longer work against this mutated form of ringworm, leaving doctors with limited options.
"It could be easily mistaken for eczema or psoriasis if tests are not conducted," Professor Armstrong-James explained, highlighting diagnostic challenges.
Because the fungus has evolved to resist conventional treatments, patients are forced to return for hospital care over many weeks or months.
This prolonged treatment process means sufferers remain infectious for extended periods, with NHS dermatology waiting times exceeding 18 weeks in some areas.
"It means many people stay infectious for far longer than they should," Dr David Denning from the University of Manchester noted.
LATEST DEVELOPMENTS
The infection causes "angry" and "formidable" red, itchy rashes that typically start in the groin, thighs and buttocks before spreading to other body parts, including the face.
"Some people won't feel like they can leave the house or go to work. They can become social pariahs," Dr Denning said.
Without treatment, the rashes become painful and inflamed, leaving sufferers vulnerable to secondary infections and permanent scarring.
"And it is very socially limiting," Dr Denning added. The psychological impact can be devastating for those affected, with hundreds now at risk of social isolation, according to experts.
The infection primarily affects women aged 20 to 59, though the youngest recorded case involved a two-year-old child, UKHSA data shows.
"It's something that we have noticed spreads in families," Professor Armstrong-James revealed.
The fungus transmits easily through shared household items, including towels, bedding and clothing, with previous reports also connecting it to sexual contact.
"We're seeing clusters. Once one person gets it, others follow," he said.
Andrew Borman from the UKHSA urged infected individuals to "limit skin-to-skin contact with others until lesions have completely resolved".

Infected individuals are urged to avoid sharing towels
|GETTY
He also advised washing clothes, towels and bedding at high temperatures and drying them thoroughly before use, while avoiding sharing towels.
The agency particularly warned clinicians to suspect the fungus in patients with groin, buttock and thigh infections who have travel connections to South Asia or when standard antifungal treatments prove ineffective.
Most reported UK cases involve people of South Asian heritage, though Dr Denning warned it "won't be long" before it spreads throughout the wider population.
Our Standards: The GB News Editorial Charter









